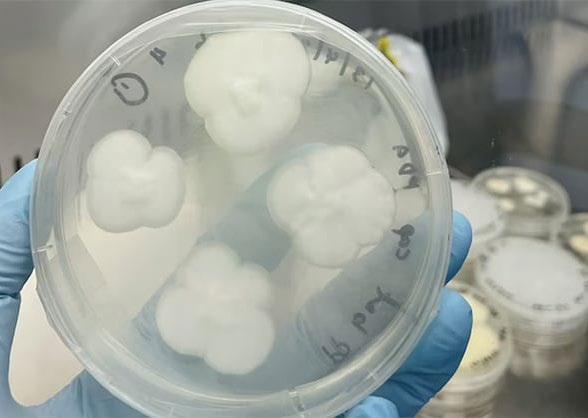

REGIÓN - PÁG. 03
DREM: 191 mineras informales se encuentran suspendidas en la provincia de Puerto Inca



REGIÓN - PÁG. 04

MPHco emitirá nuevas ordenanzas para sanear predios en AA.HH. y accedan a servicios básicos



REGIÓN - PÁG. 05
Tingo: 178 hoteles y casas de alojamientos ofrecerán sus servicios en la ExpoAmazónica 2023

PASCO - PÁG 07
Pasco: Compañía de Bomberos de Pasco demandan nuevos trajes de protección y equipos


REGIÓN - PÁG. 02
Pulgar pidió a la presidenta de la República, Dina Boluarte, atender a los pueblos amazónicos

“Exige
ASALTANTES DEJAN AMARRADOS DE PIES Y MANOS A ENAMORADOS
TERROR EN CARRETERA
REGIÓN- PÁG. 08
Enfermera denuncia abuso de autoridad y hostigamiento en la Red de Salud de Dos de Mayo
• Dos hampones interceptaron y asaltaron a una pareja de enamorados, que se transportaban a bordo de una motocicleta en la carretera de Huamantanga (Dos de Mayo). Tras amenazarlos con un arma de fuego, los asaltantes se apoderaron del vehículo y sus objetos de valor. Las víctimas fueron abandonadas atadas de pies y manos a mitad de la vía. Pág. 12
- PÁG. 13
Incautan vehículo y detienen a chofer que habría participado en robo de tienda “Nolberto” en Ambo

www.ahora.com.pe /@Diario.ahora.1 /@DiarioahoraHco /@Diarioahora
Temal Servicio al instante Jr. General Prado 254 Huánuco/Cel. 973998100 LIDERANDO LA INFORMACIÓN
el baloncito amarillo”
POLICIALES
Huánuco | Viernes 05 de mayo de 2023 Director Periodístico: Julio Trujillo Pazos N°8783 | S/. 1.00
Pulgar pidió a la presidenta de la República, Dina Boluarte, atender a los pueblos amazónicos
Alzó la voz por los exportadores y poblaciones que viven en pésimas condiciones en la selva peruana
EL DATO
Durante su visita en la capital del país, Antonio Pulgar dio una cálida bienvenida a la presidenta Dina Boluarte, quien visitó el stand de la ExpoAmazónica 2023 en Lima. El gobernador de Huánuco invitó a la mandataria a participar en el megaevento que se realizará en Tingo María en septiembre.

Antonio Pulgar, presidente de la Mancomunidad Regional Amazónica (MRA) y gobernador de Huánuco, exigió a la presidenta de la República, Dina Boluarte, más intervención del Ejecutivo en la Amazonía peruana, para impulsar el desarrollo inclusivo, sostenible y participativo de los pueblos amazónicos.
Esta demanda lo planteó en el primer Consejo de Estado Regional que se realizó en Lima. En su

exposición, Pulgar cuestionó que, en los nueve ejes principales de la política general del Estado, no se haya considerado el tema ambiental y la conservación de nuestros bosques amazónicos, en plena crisis climática.
“Quizás a la Amazonía peruana se le presta poca atención, porque solo es el 14 % de la población nacional”, expresó.
Del mismo modo, expresó que la Amazonía peruana es el territorio
con menor desarrollo en el país, con severas limitaciones en conectividad, con carreteras nacionales calamitosas, con niveles altos de pobreza y de necesidades básicas insatisfechas.
Exportadores de café y cacao
Resaltó que, para enfrentar la grave amenaza del cambio climático que afecta al planeta, es fundamental mantener en
Jefe de Laboratorio de Diresa desmiente estar inhabilitado para ejercer cargos públicos
Durante una conferencia de prensa, el biólogo Gary Orlando Burgos Vela, jefe de Laboratorio de la Dirección Regional de Salud (Diresa), desmintió que actualmente esté inhabilitado para ejercer cargo.


Como se sabe, un medio local informó que Burgos Vela estaba inhabilitado por el caso de la adquisición de estetoscopios adultos y pediátricos en el 2016 del Hospital Regional Hermilio Valdizán.
En ese sentido, calificó la información difundida por los medios como “malintencionada y falsa”. “La inhabilitación pasó hace mucho tiempo, ya estoy hábil y tengo la sentencia judicial en primera instancia que me exime de toda responsabilidad con fecha del 11 de mayo del 2022”, afirmó.
Reseñó que cuando sucedió el caso de la compra de los estetoscopios, la situación fue elevada a la Contraloría y se emitió una sanción que
fue judicializada. “En primera instancia, ya han dicho que no tengo nada que ver”, indicó.
“La información está tergiversada, yo trabajaba desde hace años con la Unheval, cuando llegó la resolución conversamos con los responsables de recursos humanos y quedé en abstenerme de seguir laborando hasta solucionar el problema. Yo vine a trabajar en la Diresa, como tercero, y ahí no hay ningún problema, pero el presiden-
pie los bosques peruanos. También puso en agenda el peligro que corre la exportación de cacao y café a los mercados europeos, a raíz de las nuevas regulaciones que exigen para productos asociados a la
deforestación ocurrida después del 2020.
Dijo que desde la MRA hay la seguridad de detener y revertir el proceso de deforestación. Explicó que cada gobierno regional tiene una Estrategia
de Desarrollo Rural Bajo en Emisiones, las cuales han sido aprobadas con ordenanzas regionales y se incorporan en los planes concertados regionales de desarrollo. En ese sentido, dijo que la MRA plantea una agenda interregional para apoyar el desarrollo rural bajo en emisiones en la Amazonía peruana. “Por eso, han planteado a los ministerios del Ambiente y Desarrollo Agrario y Riego una agenda de trabajo conjunto para tratar temas urgentes e impostergables”, resaltó.
te de ese entonces Vizcarra dijo que, quienes estaban por tercero, debían pasar como CAS”, relató.
Por su parte, la asesora legal de la Diresa, Diana Cornejo,
explicó que el cargo que tiene el biólogo no es de confianza.
“Es simplemente jefe de oficina, es una coordinación que se ha dado, pero eso no significa que cualquiera de los
otros biólogos pueda asumir este cargo. No es un cargo de confianza, pero él asume porque tiene su sentencia donde le quitan la inhabilitación”, reseñó.
02 región AHORA | Viernes 05 de mayo de 2023 región
Pulgar participando en el primer Consejo de Estado Regional.
Pulgar y Boluarte en el stand de la ExpoAmazónica en Lima.
DREM: 191 mineras informales se encuentran suspendidas en la provincia de Puerto Inca

Mientras que 61 empresas mineras informales están vigentes y regularizados por el Ministerio de Energía y Minas
EL DATO
Es de hacer notar, que la Dirección Regional de Energía y Minas tiene como objetivo promover la inversión en las actividades mineras-energéticas, en un marco legal competitivo, dentro de un desarrollo sostenible e incentivando la investigación y capacitación.
formales inscritas.
“Se van a implementar acciones para mejorar el plan de trabajo para supervisar, asesorar, controlar y evitar la minería ilegal en la zona, donde se estará buscando un personal capacitado profesionalmente, que no tenga ningún vínculo con empresas mineras, para brindar la asistencia técnica a los mineros”, indicó Herrera.
En la provincia de Puerto Inca existen 252 empresas mineras informales que están inscritas en el Registro Integral de Formalización Minera (Reinfo), de las cuales 61 están vigentes, mientras que 191 mineras informales se encuentran suspendidas.
Así indicó el titular de la Dirección Regional de Energías y Minas (DREM) de Huánuco, José Feliciano Herrera Laurencio.
Explicó que las actividades mineras informales se encuentran inscritas ante el Reinfo del Ministerio de Energía
y Minas, y la DREM se encarga de “supervisar si cumplen o no los requisitos de permanencia en el registro y, de acuerdo a los tallados que hacen en el campo, se toman las acciones pertinentes para su exclusión o permanencia”.
Aseveró que las accio-
Restringirán servicio de recojo de basura al Mercado Modelo de Huánuco por no pagar arbitrios
La Municipalidad Provincial de Huánuco (MPHco) decidió suspender el servicio de recojo de residuos sólidos al Mercado Modelo de Huánuco hasta nuevo aviso, ya que el emporio comercial adeuda la suma de un millón de soles en arbitrios y se niega a saldar el monto.
Así indicó el alcalde provincial de Huánuco, Antonio Pulgar. Explicó que dicha medida busca que la asocia-

ción de comerciantes, que dirige dicho centro de abastos, cumpla con los compromisos con la comuna.
Explicó que por ser éste un mercado privado se dirigirá a la Fiscalía del Ambiente, a la OEFA y a la Defensoría del Pueblo, para informarles sobre la medida que ejecutará la municipalidad, ya que la directiva de Mercado Modelo no paga el servicio y tampoco cumple
con las disposiciones de Defensa Civil.
Ratificó que como autoridad tiene que tomar medidas drásticas para que las instituciones o empresas privadas cumplan con sus obligaciones con la MPHco.
Sostuvo además que solicitará información al Presidente de la Corte Superior de Justicia, Jaime Gerónimo De la Cruz, y que le explique los motivos del retardo procesal
nes que ejecutan como Ministerio de Energía y Minas es hacer cumplir las normativas vigentes en materia de seguridad y salud ocupacional del medioambiente. “De incumplirse, podrían ser excluidas del proceso de formalización ante el Reinfo”, indicó Herrera.
del juicio del Mercado
Modelo de Huánuco, que lleva 17 años en proceso. Por otro lado, Jara reiteró que con el “Gobierno

Fiscalización y control
Destacó que han venido trabajando para el cumplimiento de las normativas establecidas y evitar la minería ilegal en la zona, por lo que aspiran realizar un plan de trabajo de fiscalización en las 252 mineras in-
Regional de Huánuco no tengo ningún tipo de relación y como alcalde tengo que hacer gestión, y en esto me estoy abocando”.
“Es importante contratar al personal idóneo para que lleve a cabo una labor con profesionalismo en este sector de la minería, a través de un plan estratégico con una rotación constante del personal para evitar cualquier acto de corrupción”, resaltó el director del DREM.
Por último, anunció que está trabajando en el avance para la ejecución del proyecto del Mercado de Mayoristas Señor de Puelles.
03 región AHORA | Viernes 05 de mayo de 2023 región
MPHco emitirá nuevas ordenanzas para sanear predios en AA.HH. y accedan a servicios básicos
Viviendas en zonas de riesgo no serán reconocidas por la comuna y terrenos serán delimitados con drones
EL DATO
El alcalde tendrá similar reunión con la mesa técnica constituida con los dirigentes del pueblo joven Las Moras. “Debo resaltar que las reuniones se están realizando con los verdaderos dirigentes, y no con las personas que por años han utilizado a los asentamientos para sus fines personales”, concluyó el alcalde.
Aperturan Centro de Idiomas en el Marcos Duran Martel
El alcalde de Huánuco, Antonio Jara, presidió la primera Mesa Técnica con los dirigentes del Asentamiento Humano Aparicio Pomares, donde se analizó técnicamente los procedimientos para lograr el saneamiento de los predios. En la reunión también participó el staff gerencial de la Municipalidad Provincial de Huánuco (MPHco).

Acordaron que la comuna emitirá nuevas ordenanzas conforme a ley, que permitan dar viabilidad a los trámites que están “entrampados” en la municipalidad.
“Hemos descubierto que administrativamente no han atendido los documentos que presentan los asentamientos. Algunas ordenanzas están desfa-
sadas. Vamos a debatir nuevas reglamentaciones para el saneamiento de los predios”, declaró el alcalde de Huánuco.
Usarán drones También propuso el levantamiento topográfico con drones en los asentamientos humanos para conocer la delimitación de los predios. “Los dirigentes
están en la responsabilidad de sociabilizar a sus vecinos las acciones que tomará la municipalidad”, declaró Antonio Jara.
Los técnicos de la municipalidad resaltaron que no se entregará los reconocimientos a las viviendas ubicadas en zonas de riego, y los certificados de posesión serán para acceder a los servicios básicos de agua y desagüe.

Municipalidad de Amarilis entregará 77 toneladas de víveres a ollas comunes
calización de los regidores, Annie Ysla Bazán y Pedro Pablo Esteban Cajas.
El alcalde Roger Hidalgo gestionó los alimentos a través del programa Qali Warma. Las ollas comunes beneficiadas con la primera entrega son: Yireh, Corazón Misericordioso, Hatun Rumi y Lomas de Dios, las cuales están debidamente registradas en el distrito de Amarilis.
La Escuela Superior
Pedagógico Marcos Duran Martel activó su Centro de Idioma, dirigido al público en general, donde se ofertará el idioma inglés y el quechua.

La información la dio a conocer el director del pedagógico, Elmer Serna Román, quien aseguró que se garantiza el aprendizaje de los estudiantes con la convocatoria de profesionales y especialistas en ambos idiomas.
“Estamos iniciando el funcionamiento del centro de idioma a través de la resolución 212, estamos dando apertura
para ofertar dos idiomas, Inglés y Quechua”, indicó. “Estamos en el periodo de los servicios, vamos hacer un diagnóstico y una prueba aquellos jóvenes estudiantes para que puedan nivelarse y ubicarse”, agregó. Señaló que al principio se espera abrir dos sesiones con 40 alumnos como máximo, pero aseguró que depende de la demanda se irán aperturando más. Asimismo, Serna Román afirmó que el nivel básico durará 10 meses y las clases serán en horas de la tarde.
El alcalde de Amarilis, Roger Hidalgo Panduro, informó que la Municipalidad Distrital de Amarilis cumple con entregar 77 toneladas
de víveres para las 22 ollas comunes, donde se atiende con raciones de alimentos a cientos de vecinos en situación de vulnerabilidad.
La entrega de los alimentos se desarrolló al frontis de la comuna, a través de la Gerencia de Desarrollo Social, contando con la fis-
Los víveres que recibieron son: conserva de pescado, aceite, azúcar, arroz fortificado, hojuelas de avena con quinua, mezcla de harinas extruidas, fideos, frijol y lentejas.

04 región AHORA | Viernes 05 de mayo de 2023 región
Tingo María: 178 hoteles y casas de alojamientos ofrecerán sus servicios en la ExpoAmazónica 2023
Autoridades, empresas turísticas y comerciantes se vienen preparando para el megaevento que se celebrará desde el 14 al 17 de septiembre
La provincia de Leoncio Prado espera un gran dinamismo económico con la ExpoAmazónica 2023, que se realizará desde el 14 al 17 de septiembre en Tingo María.
En ese sentido, las autoridades vienen realizando un trabajo de manera coordinada entre el Gobierno Regional de Huánuco (Gorehco), la Municipalidad Provincial de Leoncio Prado y los distritos, para lograr el éxito del evento regional, donde participarán autoridades, empresarios y turistas tanto del ámbito nacional e internacional.
En este sentido, el consejero regional de Leoncio Prado, Manuel Rosales Gar-
cía, indicó que la ciudad de Tingo María tiene muchas expectativas en la organiza-

ción de este magno evento, con el objetivo de desarrollar los territorios amazó-
Desagüe colapsado y agua servidas perjudican a los vecinos del jirón Independencia

nicos, entre ellos Huánuco.
“El evento más grande de la Amazonía peruana
servidas se secan con el sol, se convierten en polvo y tanto alumnos como vecinos del barrio viven inhalando estos polvos provocando enfermedades”, acotó.
Asimismo, la vecina ex-
EL DATO
se celebrará en la ciudad de Tingo María, cuyo escenario será la Playa Tingo, del distrito de Rupa Rupa, donde los comerciantes, empresarios, prestadores de servicios turísticos y todo el pueblo se están preparando para el éxito de este trascendental acontecimiento”, acotó.
Capacitaciones
Expresó que tendremos la visita de ocho regiones del país e invitados internacionales, donde existen más de 178 hoteles y casas de alojamiento en Tingo María, “por lo que existe la suficiente capacidad hotelera para recibir a los invitados de la ExpoAmazónica 2023”.
hortó al Ministerio de salud y a la alcaldía de Huánuco para que tome cartas en el asunto.
“Muchas de las viviendas están inundadas y sus habitantes han perdido
En la ExpoAmazónica 2023 participarán empresarios, comerciantes, prestadores turísticos y productores de los departamentos de Amazonas, Ucayali, San Martín, Loreto, Madre de Dios y Huánuco, que son miembros de la Mancomunidad Amazónica. Además vendrán invitados de Cusco y Piura.
“El costo de los hoteles posiblemente sea incrementado un poco, pero lo más importante es que se están preparando para prestar un buen servicio en esta “Ciudad de la Bella Durmiente””, señaló el consejero.
Acotó que se han venido realizando capacitaciones a los propietarios de hoteles, sitios turísticos, restaurantes, entre otros, para que presten un adecuado servicio a todos los visitantes durante esta expoferia.
varios enseres por el desborde de aguas servidas, esperamos que las autoridades tomen conciencia y se aboquen a solucionar los problemas de la población”, finalizó.
Los vecinos de la cuadra 12 del Jirón Independencia continúan esperando respuesta por parte de las autoridades para solucionar el colapso del sistema de desagüe, la cual viene poniendo en peligro la salud de los escolares y residentes.
De acuerdo a la denuncia presentada por uno de los vecinos, que solicitó no ser identificado, la problemática viene siendo denunciada desde principios de año y aún ninguna autoridad se ha hecho presente.

“Esta situación lleva
más de 15 años y a principios de año comenzamos a llevar solicitudes para que nos apoyaran, pero hasta ahora nada, hago un llamado a las autoridades , al Ministerio de Educación, porque aquí cerca hay un colegio y, cuando esas aguas
05 región AHORA | Viernes 05 de mayo de 2023
AHORA
Director:
Julio Trujillo Pazos
 Edita: JTP Editores
Edita: JTP Editores
Depósito Legal Biblioteca
Nacional: 99-4295
Direccion:
Jr. Crespo y Castillo N° 375
Telefono: (062) 512606
San Juan Alvarado en el teatro
Desafiante apareció el exgobernador regional de Huánuco, Juan Alvarado Cornelio, en la última audiencia judicial por el caso “Los Negociadores de la región”. A parte de negar los cargos en su contra y mostrarse como un pan de Dios, el exprofugo de la justicia, que estuvo fugado casi un año, solicitó que le cambien la medida de 18 meses de prisión preventiva que cumple en la cárcel por un arresto domiciliario. ¡Qué tal raza!
En un discurso digno de ser premiado con un Oscar al mejor actor, Alvarado manifestó a la magistrada que él “había metido la pata, pero no la mano”. Lo dijo interpretando un papel de víctima que ni él mismo se lo cree.
Muy serio e indignado afirmó que le habían violado los derechos. ¿Usted qué opina? Un poquito difícil de creer, ¿cierto? Le faltó gritar destempladamente “Soy inocente”, como Fujimori.
Al menos los que vimos la audiencia vía Facebook, no pudimos evitar reír a carcajadas con sus ocurrencias. Si sigue así le puede quitar la chamba a Carlos Álvarez.
Lo mínimo que debería hacer el señor Alvarado es pedir perdón por el gran daño que le hizo a Huánuco, por dejar a la región en el atraso, la miseria y la corrupción. Y no solo eso, lo más grave, por los más de 2000 ciudadanos fallecidos durante la pandemia del COVID-19, por la inacción, incapacidad y la falta de cálculo político para tomar decisiones durante sus tres años de gestión.
Gracias a Juan Alvarado Cornelio y compañía, cientos de sectores y organizaciones han quedado permanentemente postergadas, por la ambición desmedida, la escasa preparación, la falta de escrúpulos e infames intenciones que ha tenido este personaje al momento de gobernar la región.
Juan Alvarado lo único que ha demostrado es que sigue pensando que puede engañar a todo el mundo con su “veintiúnico” cuento que tiene, donde nos intenta convencer que es buenito, que no ha robado a nadie , que es un angelito, aunque todo indique lo contrario.
Para los que lo conocimos alguna vez, cuando era presidente del gobierno regional Andrés Avelino Cáceres, teníamos toda la impresión y convicción de que era un hombre honesto, amable y era un profesor a carta cabal. Pero la ambición y el poder lo emborracharon, además de su entorno tóxico, terminó por hacer de la región su patio de juego. Donde hijos, amantes y chupamedias arreglaban todas las obras. La misma investigación de la Policía y la fiscalía arrojó eso.

Ahora está preso en Potracancha, qué triste final para un profesor de primaria. ¿Dónde quedó su apellido? ¿No pensó en el bienestar de sus hijos? ¿No pensó en su mujer, sus nietos?
Vergonzosamente, de amigo de Huánuco se volvió enemigo.
Tal vez algo positivo pueda salir de esto, un nuevo santo, San Juan Alvarado, ha nacido, a quien podemos rezar para que llegue ‘platita’. Quién sabe, tal vez funciona como le funcionó a él.
Ventas: (062) 512606999 608 813
Contacto: ahorahco@gmail.com
Crear una organización adaptable
Augusto Kanashiro Castañeda
La adaptación en el mundo empresarial no es distinta de la adaptación en la naturaleza, en el sentido de que requiere la evolución constante de distintos atributos para que la entidad sobreviva. En la naturaleza, una especie sobrevive cuando se adapta física, fisiológica y psicológicamente, al tiempo que modifica su papel en la cadena alimentaria, su finalidad.
En el mundo empresarial, los atributos adaptativos son sorprendentemente similares. Las organizaciones deben cambiar físicamente adoptando nuevas tecnologías y procesos, al tiempo que inventan nuevos productos y servicios. También deben cambiar su fisiología, su forma de trabajar, la manera en que sus productos, servicios y procesos crean o no valor. Su psicología, su forma de pensar, también debe cambiar, empezando por asumir plenamente la necesidad de adaptación y la responsabilidad de todos los miembros de la organización de adaptarse. Y por último, ellos también deben examinar su papel en la cadena alimentaria y estar abiertos a ocupar un lugar diferente en esa cadena, estableciendo un propósito diferente.
Una vez más la naturaleza nos empujó a seguir adelante y dejó en claro que la adaptación es la clave de la supervivencia. De un día para el otro lo que parecía imposible se hizo posible: fuerza de trabajo 100 % remota, atención a clientes solamente por canales digitales, procesos de onboarding digital como único modo de abrir una cuenta, implementación de nuevas tecnologías en tiempo récord, y mucho más.
La pandemia de COVID-19 despejó las dudas sobre el éxito de la Transformación Digital como paradigma a seguir y dejó en claro que no era suficiente. En lugar de quedarse en la superficie y añadir capas de tecnología para perfeccionar lo que ya se ha hecho en una organización solo para hacerla más rápida o eficiente, es hora de tomarse a pecho las lecciones transformadoras del COVID-19 y abrazar el camino de la Adaptación Infinita. Es el único camino para lograr un crecimiento prolongado en el tiempo y estar preparados para que el cambio que se avecina no ofrezca más que oportunidades.
Veamos más de cerca cómo, paso a paso, una organización puede volverse más adaptable y, a partir de ahí, lograr una ventaja competitiva sostenible y el éxito empresarial:
PRIMER PASO:
Aceptar la necesidad de que todos los componentes de la empresa se adapten, desde cada proceso y producto hasta cada departamento y empleado, incluidos los miembros de la cúpula directiva.
SEGUNDO PASO:
Aceptar que la psicología de la adaptación es lo más crítico y lo más difícil de hacer. Adquirir nuevas tecnologías, cambiar procesos e incluso redefinir objetivos es fácil comparado con la tarea de cambiar la forma de pensar, creer y actuar de una organización y su gente. Las empresas deben hacer del cambio de comportamiento y mentalidad de arriba abajo un objetivo primordial, apoyado por una comunicación constante entre los líderes, sistemas de gestión y desarrollo del rendimiento y programas de incentivos y reconocimiento.
TERCER PASO:
Crear canales bidireccionales directos con el entorno externo e interno. Como sugiere la definición, la adaptación es la modificación de un organismo o de sus partes que lo hace más apto para la existencia. Más apto significa estar más en sintonía con su entorno y con todo lo que éste presenta. En el caso de las empresas, deben mejorar su capacidad de entender el entorno como clientes, competidores, competidores indirectos, tecnologías emergentes, tendencias sociales, normas culturales internas y expectativas cambiantes de los empleados.
CUARTO PASO:
Reajustar el plan estratégico y operativo para responder a las verdades constatadas del entorno como oportunidad o amenaza. El reajuste requiere la voluntad de desprenderse de prácticas, productos e incluso creencias heredadas y la voluntad de adoptar un nuevo nivel de asunción de riesgos en toda la organización. La adaptación es un cambio, y la mayoría de las organizaciones ven el cambio como un riesgo.
QUINTO PASO:
Crear nuevas medidas de rendimiento que reflejen el progreso de la adaptación, porque lo que no se mide no se puede mejorar. Aunque las medidas estándar de los cuadros de mando corporativos, como los beneficios, la rentabilidad del capital y el crecimiento orgánico, siguen siendo válidas, en la era de la adaptación debemos incluir ahora medidas como el crecimiento del capital de conocimiento, el tiempo que se tarda en llegar al cliente y la elasticidad cultural.
En un contexto internacional, cada vez más complejo y cambiante, la adaptabilidad es una habilidad crucial tanto para los líderes como para los empleados de sus organizaciones.
El mundo parece moverse de forma cada vez más veloz y las instituciones deben adaptarse rápidamente a las tendencias emergentes, las tecnologías disruptivas, los cambios regulatorios y las condiciones económicas en constante evolución, para mantenerse competitivas y satisfacer las necesidades en constante evolución de los clientes.
06 ópinión AHORA | Viernes 05 de mayo de 2023
César
editorial
opinión
Compañía de Bomberos de Pasco demanda nuevos trajes de protección y equipos
Recibieron saludos por el Día Internacional del Bombero
EL DATO
Actualmente, el Cuerpo General de Bomberos Voluntarios del Perú cuenta con 208 Compañías de Bomberos Voluntarios, en todo el territorio nacional, y tiene más de doce mil integrantes, de los cuales el 37 % son mujeres.


Jorge Rau López, primer jefe teniente - brigadier de la Compañía de Bomberos de Pasco, recibió el fraterno saludo de las autoridades por el Día Internacional del Bombero, que se celebró ayer, 4 de mayo.
Rau López agradeció el saludo y se comprometió a
continuar trabajando junto a los integrantes de la Compañía Salvadora Cosmopolita nº 17 de Pasco, en la atención de urgencias y emergencias que requiera la población pasqueña.
Mencionó que el 4 de mayo se celebra el Día Internacional del Bombero,
fecha para homenajear a aquellos hombres que ponen en riesgo su vida apagando los incendios, rescatando personas y asistiendo a la población durante los desastres naturales.
Manifestó que, en Cerro de Pasco, los integrantes de la gloriosa compañía nece-
sitan trajes de protección personal, puesto que los que usan ya cumplieron su tiempo de vida, de igual manera, demandan unidades móviles y algunos equipos. Recordó que los integrantes del cuerpo de bomberos realizan una labor sin retribución económica.
La celebración del Día Internacional del Bombero, surge en 1999, cuando en la ciudad de Linton, Australia, se propuso rendir homenaje a los hombres de rojo, tras el fallecimiento de cinco bomberos que intentaban apagar un incendio forestal.
pero sobre todo las bombardas y los fuegos artificiales iluminan las noches de esta ciudad minera.
Ag rupaciones de danzantes como “Los Capullos de San Cristóbal”, elenco integrado por jóvenes y señoritas que incursionan en la danza, se puede apreciar durante horas por las principales calles, así como también, la Asociación 3 de Mayo, que cumplió 53 años de vida institucional, continúa vigente y danzando.

La Contraloría General efectuó 42 servicios de control, desde enero hasta el mes de abril de este año, para cautelar los recursos públicos en la región Pasco, a través del servicio de control simultáneo y posterior a las diferentes entidades públicas. Se informó además que actualmente otros 24 servicios de control se encuentran en ejecución.
El encargado de exponer los principales resultados obtenidos durante el primer cuatrimestre del 2023, en una jornada informativa a los medios de comunicación de la región, fue el gerente
regional de control de Pasco, Edwin Gonzales Boza, quien precisó que, de los servicios de control realizados, 30 corresponden al control simultáneo y 12 al control posterior.
Entre los principales informes emitidos destacan la Visita de Control N° 004-2023-OCI/5348-SVC al Gobierno Regional de Pasco para advertir la ejecución de trabajos en la construcción del Hospital Román Egoavil Pando, distrito Villa Rica, sin contar con el control técnico, autorización y aprobación por parte de un supervisor de obra.
2023
El desarrollo de las fiestas de las Cruces de Mayo obliga a que los mayordomos quieran sobresalir y compitan entre
ellos, por ello, durante estos días, el eco de los cohetes durante el día y la noche son constantes.
La presentación de los
elencos de danzas típicas como la Chunguinada, la Negrería, entre otras, acompañan las frías noches en Cerro de Pasco,
Esta agrupación está integrada por hombres y mujeres transgénero, que integran parejas de 8 bailantes y acompañados de los chutos y mayordomos también recorren las calles.
El Centro de Cultura Popular Labor de Cerro de Pasco, la Red Muqui de Lima, Comundo Suiza y la Mesa de Concertación para la Lucha contra la Pobreza de Pasco, vienen organizando el III Programa de Capacitación e Integración Juvenil Pasco 2023, denominado “Jóvenes líderes frente a la problemática socioambiental de Pasco”.
El evento está dirigido a varones y mujeres de los diferentes distritos, de la provincia de Pasco, que soportan
problemas socioambientales, producto de los impactos negativos de la actividad extractiva minera.
Durante el 2021 y 2022, se han desarrollado el I y II Programa de Capacitación e Integración Juvenil, los cuales han servido para que los jóvenes fortalezcan sus conocimientos sobre la temática de salud ambiental y humana, y con ello participaron en acciones de incidencia con autoridades a nivel local y nacional.

07 PASCO AHORA | Viernes 05 de mayo de 2023 PASCO
Con bombardas, castillos de fuegos artificiales y música, Cerro de Pasco celebra las fiestas de las Cruces de Mayo
Contraloría ejecutó más de 40 servicios de control simultáneo y posterior en Pasco
Jóvenes participan en el III Programa de Capacitación e Integración Juvenil Pasco
Enfermera denuncia abuso de autoridad y hostigamiento en la Red de Salud de Dos de Mayo
Acusa que pretenden rotarla al Puesto de Salud de Rondos sin ninguna justificación
La enfermera Elizabeth Cadillo Albino denunció que los directivos de la Red de Salud de Dos de Mayo estarían atropellados sus derechos y actuando arbitrariamente en su contra, ya que le han ordenado su rotación sin justificación alguna, aseveró.
Asimismo, culpó a la obstetra Kira Tucto Tarazona de estar detrás del presunto abuso de autoridad.
Cadillo, quien labora en la Red de Salud Ripán desde hace 10 años por contrato CAS determinado, sostuvo que el pasado 27 de abril la Red de Salud de Dos de Mayo le envió un memorándum informando su rotación al Puesto de Salud de la Microred Rondos, en la provincia de Lauricocha, pero advierte que dicho memorándum no dice el tiempo que se está rotando.
“El miércoles me acerqué a hablar con la directora y me
han dado respuestas inapropiadas o poco fundamentadas. La entidad puede rotar el personal siempre y cuando haya una falta disciplinaria, todo esto es un proceso que en mi caso se ha omitido. Yo desconozco cualquier informe negativo que se haya hecho en mi contra, hasta
la fecha desconozco”, dijo al Diario Ahora.
Lamentó que el trámite sea a la jefa de microred, quien debió haber recibido un informe sobre una queja de un paciente o un colega, lo cual hasta ahora la profesional desconoce. “Debería haberme hecho conocer la
supuesta queja en mi contra, no lo ha hecho y lo envió directamente a la red”, indicó.
“Tengo la seguridad que es la obstetra Kira Tucto Tarazona, que me viene hostigando, quien ha presentado los documentos y existe amistad entre ella y la directora. Pido que se evalúe esta
Empresa de turismo Cayhuayna solicita
“De acuerdo a lo que dice la ley, ellos deberían estar
prestando servicio de taxi, mas no de transporte públi-

rotación, porque el proceso que se ha realizado no es el correcto, se está haciendo abuso de autoridad, cambiarme de la noche a la mañana eso no se hace”, puntualizó.
En ese sentido, recordó que la obstetra Kira Tucto Tarazona tiene varias denuncias por hostigamiento, el último que se le abrió ocurrió el año pasado, sin embargo, agregó que “continúa laborando como si nada”.

Le negaron defenderse
“Me dicen que son muchos informes graves, han estado almacenados y yo los desconozco. Hicieron una evaluación y no he hecho mi descargo, me negaron mi derecho a la defensa”, acusó Cadillo.
La profesional de la salud aseguró que esta situación le está perjudicando, por lo que pidió que se reconsidere la decisión de su rotación.
co, pero la municipalidad les permite ofrecer el servicio de colectivo, nosotros no tenemos nada en contra de eso, pero lo que sí pedimos es que nos dejen hacer la ruta ida y vuelta, ya que es lo más
EL DATO
Elizabeth Cadillo aclaró que no tiene problemas con la directora, pero sí con las personas que están detrás del supuesto informe en su contra. Aseguró que la principal interesada en su rotación sería la obstetra Kira Tucto Tarazona.
Además reconoció que en la microred de Salud de Ripán se vive un mal ambiente laboral.
“La microred de Ripán es conocida por los conflictos de los personales nombrados, ahí uno no puede decir lo que piensa, porque ya te señalan, al sentirse que son nombrados, sienten que pueden tener más poder sobre nosotros, hay colegas que han puesto la denuncia a la directora y han hecho su informe al personal nombrado por hostigamiento”, denunció.
lógico”, indicó.
Finalmente, Liberato Soto aseguró que desde el año pasado han venido solicitando dicha ampliación, sin embargo, agregó que hasta ahora no reciben respuesta.
El representante de la empresa de Turismo Cayhuayna , Liberato Soto Vega, solicitó a la gerencia de Transporte de la Municipalidad Provincial de Huánuco (MPHco) la ampliación de la ruta Andabamba-La Esperanza y La Esperanza-Huánuco, ida y vuelta.
Según el dirigente, la Gerencia de Transporte no ha aprobado dicha ampliación debido a que existen empresas pequeñas de colectivos que se oponen. Sin embargo, indicó que muchos de ellos no deberían estar prestando el servicio de transporte público.

08 regional AHORA | Viernes 05 de mayo de 2023 regional
que se modifique ruta La Esperanza- Huánuco
COVID-19 sin sustento técnico ni legal
En el 2020, Minsa adquirió “Vasopresina” para pacientes en estado shock séptico
de Abastecimientos de Recursos Estratégicos en Salud (CENARES) pagó a la empresa Pharmaceutical Distoloza S.A. el importe de S/23 760 000 por la compra de unidades del medicamento Vasopresina.
La solicitud de dicha compra se hizo en mayo del 2020 y fue formulada por la Dirección General de Operaciones en Salud (DGOS) del Minsa.
Sin embargo, según indica el informe, “dicho medicamento no estaba considerado en el Petitorio Nacional Único de Medicamentos Esenciales para el Sector Salud, ni en los productos farmacéuticos esenciales para el tratamiento de la COVID-19 determinadas por el Minsa”.
Congreso: Gobernadores y alcaldes rendirán cuentas de trabajo hasta último día de gestión
La Contraloría General de la República detectó que, entre julio y octubre del 2020, el Estado percibió un perjuicio económico de más de S/21 millones en un medicamento contra la COVID-19 que no tenía sustento
técnico ni legal para ser aplicado a los pacientes.
Según el Informe de Control Específico N° 0062023-2-0191-SCE, el Ministerio de Salud (Minsa) adquirió 480 mil unidades del fármaco Vasopresina, por contrato directo, pese
a que no había sustento de la necesidad de su aplicación “en el tratamiento de pacientes con COVID-19, en estado de shock séptico”.

El documento revela que, entre los meses referidos, el Centro Nacional
Además, tampoco “se obtuvo la autorización de la Dirección General de Medicamentos, Insumos y Drogas (Digemid) para realizar dicha compra, y no existía desabastecimiento de los vasopresores de primera elección que sí se utilizaban en el trata miento del coronavirus”.
El Congreso aprobó por unanimidad el proyecto de ley que asegura que los gobernadores regionales y alcaldes rindan cuentas de su trabajo hasta el último día de su gestión, con la firma de un acta suscrita con la comisión de transferencia de funciones, bajo la supervisión de la Contraloría.
Durante la sesión de este miércoles, la legisladora Norma Yarrow (Avanza País), autora del proyecto, explicó que se busca precisar que la función de una autoridad regional o muni-
cipal concluya con la firma de la referida acta.
Con ello, la comisión de transferencia deberá dar conformidad de que recibió toda la documentación necesaria sobre la gestión municipal.
“Esto obliga al gobernador o alcalde a rendir cuentas hasta el último día de gestión del saliente, para que la autoridad entrante pueda tener una responsabilidad documentada y no se justifique diciendo que no le entregaron nada”, señaló.
Detectan brote de influenza H1N1 en Lima y otras tres regiones del país

José Williams tilda de sesgada
el
informe de la CIDH sobre protestas sociales
parte de la Policía y las Fuerzas Armadas, también se hayan violado los derechos humanos, durante las protestas contra el gobierno de Dina Boluarte.
“Hay injerencia, sesgo y esto tiene que ver con nuestra soberanía sobre competencias y capacidades como Estado. Tenemos la suficiente capacidad como para nosotros solucionar problemas, pienso que no necesitamos una organización multinacional que vaya hacer la tarea
de la Fiscalía, tenemos las personas preparadas para ello”, señaló el titular del Parlamento.

Asimismo, agregó que no coincide con “las matanzas que han habido”, así como los términos “masacres y ejecuciones extrajudiciales”.
“Tampoco he visto que se hayan referido a la violencia por la que fueron atacadas las fuerzas del orden, porque ha sido organizada con piedras, ladrillos, adoquines, eso ha sido fuerte”, dijo.
Las autoridades sanitarias del país detectaron un brote de influenza H1N1 que se presenta en, al menos, cuatro regiones, principalmente en Lima Metropolitana, informó el director del Centro Nacional de Epidemiología, Prevención y Control de Enfermedades (CDC Perú), César Munayco.

“Tenemos un brote a nivel de Lima Metropolitana. Tenemos también a Tacna, Tumbes, Loreto, pero se está afectando a niños menores, por eso es importante la vacuna-
ción y las medidas preventivas que ya conocemos”, declaró Munayco.
El funcionario del Ministerio de Salud (Minsa) remarcó que los menores de edad son el grupo más afectado por esta enfermedad y pidió a los padres que no los envíen a las escuelas si presentan síntomas respiratorios, para evitar la propagación del brote.
Munayco detalló que se debe prestar especial atención a síntomas como el malestar general, tos, somnolencia y respiración agitada.
09 NACIONAL AHORA | Viernes 05 de mayo de 2023 NACIONAL
Más de S/23 millones se gastaron en fármaco contra la
El presidente del Congreso, José Williams, cuestionó que el informe
final de la CIDH haya concluido que existió un uso desproporcionado de
internacional
Descubren hongo que puede reciclar el plástico
peligrosos al aire. Solo el 5% de los plásticos se reciclaron en nuevos artículos, según NPR .
Lisa Ramsden, activista sénior de plásticos de Greenpeace USA, le dijo a NPR en ese momento que las industrias podrían triplicar la producción de plástico para 2050, lo que agravaría el problema.
“Se produce más plástico y se recicla un porcentaje
aún menor”, dijo
a NPR.
Según la Columbia Climate School , el reciclaje de plástico sigue siendo un desafío importante en la industria de los desechos porque a menudo está contaminado con alimentos y otros artículos.
Cabe mencionar que Estados Unidos generó 292,4 millones de toneladas de desechos sólidos municipales en 2018, y solo 94 millones de toneladas, o alrededor del 32 %, se reciclaron o convirtieron en abono, según la Agencia de Protección Ambiental de EE. UU . Mientras tanto, unos 146 millones de toneladas (o el 50 %) de los
desechos se depositaron en vertederos y 35 millones (o alrededor del 12 %) de toneladas se quemaron, según la agencia.
En la Universidad de Sydney, los científicos están probando el proceso de degradación de los hongos para ver cómo pueden hacerlo más eficiente y listo para su uso a escala comercial, según la Australian Broadcasting Corporation. El proceso de investigación podría tomar los próximos tres a cinco años, dijo Abbas, y agregó que, mientras tanto, sería necesario abordar una letanía de problemas de comportamiento y comerciales.
Un grupo de científicos de la Universidad de Sydney descubrieron a través de experimentos que podían usar dos tipos de moho que se encuentran comúnmente en las plantas y el suelo, Aspergillus terreus y Engyodontium album, para descomponer el plástico resistente, según los hallazgos publicados en la revista científica npj Materials Degradation, el australiano Broadcasting Corporation.

Los hongos tardaron unos 140 días en descomponer por completo los plásticos probados.
“Es la tasa de degradación más alta reportada en la literatura que conocemos en el mundo”, dijo Ali Abbas, profesor de ingeniería química en la universidad.
Es una noticia optimista después de que un informe
de 2022 de Greenpeace descubriera que la gran mayoría de los plásticos que se reci-
clan en los EE. UU. terminan en el océano o en vertederos, que emiten contaminantes
SANEAMIENTO FISICO LEGAL DE INMUEBLES MINISTERIO DE EDUCACION

De conformidad con los artículos 21,22 y 23 del TUO de la Ley Nº 29151, en virtud del artículo 251 de su reglamento D.S Nº 008-2021-VIVIENDA, pone en conocimiento que se viene efectuando el saneamiento físico legal de los predios, ubicado en la región Huánuco, Acto Registral Artº 243: 1.-Acto Registral: Independización, Uso institución educativa – Predios Sin Saneamiento:
01.- I.E. Nº 32289 (Antec. Reg. P.E Nº 11031073) área: 8,341.95 m2, Perímetro: 365.89 ml, distrito de Chavinillo, provincia Yarowilca; 02.- I.E. Nº 33424 - Nivel Secundaria, (Antec. Reg. P.E Nº 11162752) área: 11,071.00 m2, Perímetro: 420.42 ml, anexo de Condorgaga, distrito Huacrachuco, provincia Marañón; 03.- I.E. Nº 32129 (Antec. Reg. P.E Nº 11170268) área: 1,208.05 m2, Perímetro: 158.94 ml, distrito de Amarílis; 04.- I.E. Nº 33367 (Antec. Reg. P.E Nº 11108680) área: 9,934.01 m2, Perímetro: 388.87 ml, distrito de Chinchao de la provincia de Huánuco.
UROLOGO

DR. SAHIR SALAS MIÑANO
Jr. Crespo Castillo Nº 581
Atención: Lunes a sábado de 9-1 p.m y 4-9 p.m. Cel. 989364781 / 942449944 RPM: #942449944


10 internacional AHORA | Viernes 05 de mayo de 2023
Ramsden
GRADO HOSPITAL ALMENARA
POST
UROGINOMEDIC
Mg. Heber Alfredo Huaynate Bonilla Director Regional de Educación Huánuco
SOPA DE LETRAS
Día Internacional de los Bomberos
B F O R K I W D N R X Q T D S A
E D D M K N Q R M U F C N C N R L I P C X S E O D
S E G B M R T U W Y Y B A O B H O E K J C Y E N O
A L K C G G Z Z E W F N A R C P F N X R O P S A S
G B Y E M B B U X I R J K J R I C D T H S S P S A
J O Q E K C P N B E Q L Q Y E H M O M M W H A B M
J M Y W L E P D T O U K O I S X X I S I W I C V D
C B V S E L B N K Z Y Y F Y C E E C E Y Y V I T M
N E E P S R I P A H M R O U A O S J M N Q R O F S
W R F U E A L E G O G O G V T P D Z O P T D S X I
L O U W Í J D T Y D R N O Z E R T E T U Q O V A M
R I T D S S X N K J P K E N R I E S G O V P D P H
T G J O E V Q E M X H N H U Q K D K B C E E J P C
Q G U O A L A C O M U N I D A D S U S V I D A S O
B B R E I X B M R A C D Y F W S R Q E X C T X T V
P É E B U M J E D E I N C E N D I O S I G E F H T
H E N A P O Y O Y P R O T E C C I Ó N X Y B C S V
ª reconocimiento
ª denominados ª Héroes de Azul ª mayo se
ª celebra el ª Día Internacional ª del Bombero
ª por su labor ª en apoyo ª a la comunidad ª poniendo
ª en riesgo ª sus vidas ª en la extinción ª de incendios
ª rescate ª de personas ª y protección ª de espacios
OPERACIONES MATEMATICAS SODOKU UNIR


Aries
ARIES (21 de marzo - 20 de abril)

A pesar de los reproches de tu pareja, estos días no podrás dedicarle demasiado tiempo a las cosas de la casa, porque tienes compromisos profesionales.
TAUrO
(21 de abril - 20 de mayo)
TAURUS
Si trabajas en relación con el público en general, este será un buen día para ti, porque tu capacidad para expresarte y convencer será muy buena hoy.
GÉMINIs
(21 de mayo - 22 de junio)
GEMINI
La falta de fuerzas y la escasa energía que corre por tus venas hoy te impedirán desarrollar todo tu habitual potencial. Pasarás la jornada sin pena ni gloria.
CÁNCer
(22 de junio - 22 de julio)
LABERINTO
CANCER
No te preocupes en exceso por los problemas de salud por los que atraviesas, son algo pasajero, pero si te obsesionas podrías agravar lo que solo es una tontería.
LeO
(23 de julio - 23 de agosto)
Tu humor es contagioso y creas buen ambiente allá por donde vas. No obstante, en estos quizá sería bueno que buscaras a alguien con quien desahogarte.
VirGO
VIRGO (24 de agosto - 23 de septiembre)
Se van a producir ciertos cambios en tu entorno laboral que no te van a afectar a ti directamente, pero sí a algunos compañeros. Perjudicará el buen ambiente.
LibrA
(24 de septiembre - 22 de octubre)
Sigues pletórico de fuerzas, no hay quien te pare. Tendrás buenas expectativas para todo lo relacionado con las ventas y los negocios, con contratos muy ventajosos.
esCOrpiO
SCORPIO (23 de octubre - 20 de noviembre)
Tienes que revisar tu método de trabajo, porque por un defecto de ese método puedes estar perdiendo mucho tiempo y no poco dinero. Analízalo paso a paso.
sAGiTAriO
(21 de noviembre - 21 de diciembre)
Dale tiempo a tu pareja antes de reprocharle nada, no os conviene tensionar la relación porque las circunstancias que os afectan ya son bastante complicadas.
CApriCOrNiO
CAPRICORN (22 de diciembre - 20 de enero)
De poco te valen tus ilusiones y esperanzas si no tienes con quién compartirlas. Cada día que pasa se hace más necesario que encuentres una pareja. Mal día en casa, es my posible que tengas averías importantes que trastoquen la marcha normal del hogar.
ACUAriO

AQUARIUS (21 de enero - 19 de febrero)
La relación con algunos compañeros complicará la jornada más de lo habitual, a pesar de que en el trabajo todo marcha bien. Procura no echar leña al fuego. Los niños son niños, pero cada día que pasa lo son menos.
pisCis

PISCES (20 de febrero - 20 de marzo)
Es el momento de retomar las actividades de ocio que habías abandonado por la falta de tiempo, le vendrá muy bien tanto a tu cuerpo como a tu espíritu.
/@Diarioahora /@Diario.ahora.1 amenidades 11 amenidades AHORA | Viernes 05 de mayo de 2023
/@DiarioahoraHco
HORÓSCOPO A F E F S W F I C T Y M T J V N M U X Q A N A Q Q M V C I M A Y O S E F O E X P C E L E B R A E L D B U W D B R Z X H R L X Z R K V E T I I W X R M E I H S B V J P O V A E N L A E X T I N C I Ó N D N E P R P X L H X H O O K K J B A L J L Y C Y X E O N B B K W D P O R S U L A B O R A A Z R B L A P M T Y A C Y D S C B E X I B Q T A N P D S S J A E I A Z P X B X G I I N C Y X K R O E O H U I K S R N L Q U O L C K J X
Asaltantes ataron de pies y manos a pareja de enamorados en la carretera de Dos de Mayo
Tras amenazarlos con un arma de fuego, les robaron la motocicleta con que se movilizaban y sus pertenencias
Policías de la comisaría de Dos de Mayo iniciaron con la búsqueda de los dos delincuentes que provistos de armas de fuego asaltaron a una pareja en la carretera de Huamantanga, en la provincia de Dos de Mayo (Huánuco).
Según las investigaciones, Edward Chávez Solórzano (21) y Jaqueline Cruz Huamán (22) se dirigían a su domicilio, a bordo de una motocicleta, de marca Ronco, de placa de rodaje 4303 KW, luego de haber participado de una reunión social en Guellaycancha.
Sin embargo, al llegar a la zona de Huamantanga fueron interceptados por dos sujetos, quienes lo encañonaron con un arma de fuego, luego a Edward Chávez le despojaron de
su motocicleta, su celular, marca Redmi 12 PRO, sus zapatillas y 1300 soles en efectivo. La misma suerte
corrió Jaqueline Cruz, ya que le sustrajeron su celular Samsung A20, sus zapatillas y su dinero.
Los malhechores antes de huir ataron de pies y manos a sus víctimas, luego huyeron con rumbo
Poblador resultó herido tras ser arrastrado por sus caballos en Margos

Vidal Ramos Santiago (63) resultó herido tras ser arrastrado por
sus caballos. El hecho se registró el último miércoles, por la tarde, en la
estancia denominada “Tanara”, en el distrito de Margos - Huánuco.
desconocido. Tras desatarse por sus propios medios, los agraviados acudieron a la comisaría de
Dos de Mayo para asentar la denuncia.
Asalto a Judith Toribio El atraco ocurrió la noche del último miércoles. Los agentes, alertados del hecho, realizaron diversos operativos a fin de ubicar e identificar a los malhechores, sin embargo, hasta el cierre de edición de este diario no han obtenido resultados favorables.
En tanto, los pobladores se encuentran alarmados por la presencia de delincuentes con armas de fuego. Dado que, hace unos días, también asaltaron a la atleta Judith Toribio, a quien le interceptaron y, tras encañonarla con un arma de fuego, le despojaron de sus pertenencias.
Adolescente fue retenido por golpear a su padre en Tingo María

Se conoció que el accidente ocurrió cuando Ramos Santiago amarraba sus caballos, de repente, la soga se enredó en su pierna derecha y fue arrastrado violentamente por varios metros por uno de los caballos.
El poblador terminó malherido sin poder caminar, por lo que tuvieron que solicitar ayuda a los policías y serenos, quienes llegaron a la zona, luego de varios minutos de caminata y auxiliaron al poblador.
El herido fue trasladado con una camilla al centro de salud de la zona para brindarle los primeros auxilios y sanar sus heridas.
El adolescente, identificado con las iniciales J. S. P. (17), fue retenido por policías de la Comisaría de Tingo María, tras ser acusado de golpear a su padre. El hecho habría ocurrido en su vivienda, ubicada en la cuadra seis de la avenida Amazonas, en Tingo María.

Según se supo, el menor habría atacado a puñetazos y lapazos a su progenitor de
47 años, quien denunció el hecho en la comisaría. Los policías salieron en busca del agresor, quien fue retenido y trasladado a la dependencia policial.
El menor es investigado por la presunta infracción a la ley penal violencia contra las mujeres y los integrantes del grupo familiar, en la modalidad de violencia física y psicológica a su progenitor.
12 POLICIALES AHORA | Viernes 05 de mayo de 2023 POLICIALES
Incautan vehículo y detienen a chofer que habría participado en robo de tienda “Nolberto” en Ambo

Policías de la División Macroregional de Inteligencia de Huánuco incautaron el vehículo, Tico plomo, de placa de rodaje AM-5916, al pesar sobre él una disposición fiscal de incautación, al ser sospechoso de haber sido usado en robo de celulares de una tienda.
Los agentes informaron que el carro era conducido por Víctor Gines Ponciano Soto. Asimismo, indicaron que el vehículo y el conductor habrían participado en el robo perpetrado en la tienda de celulares “Nolberto”, ubicada en la ciudad de Ambo.

Se conoció que el hecho delictivo ocurrió el 30 de noviembre del 2022, luego de las investigaciones, los policías habrían establecido que
el vehículo de color plomo habría participado en el robo, y no se descar-
ta que el conductor esté implicado en el hecho delictivo.
El vehículo y el conductor fueron trasladados a la Comisaría de

Detienen a sexagenario acusado de hurto
quien viene investigando el caso, para determinar responsabilidades.
Cae requisitoriado que fue atrapado con más de 5 kilos de marihuana

Reynaldo Bernardo
Castañeda (63) fue detenido por policías de la Comisaría de Tingo María, tras ser acusado de haber participado de un hecho delictivo en
agravio de Norma Carmela Mendoza Isla (38).
La detención del hombre ocurrió tras la denuncia de la agraviada, quien acusó al sujeto de haber hurtado
sus pertenencias de su inmueble, ubicado en avenida La Bandera n. 299.
El sexagenario fue trasladado a la comisaría del sector para
ser investigado por la presunta comisión del delito contra el patrimonio, en la modalidad de hurto agravado, y determinar su responsabilidad en el hecho.
Renato Jerciño Argandoña Aguirre (26) fue detenido por policías de la Unidad de Emergencia al contar con una orden de captura, tras ser acusado por la presunta comisión del delito de promoción o favorecimiento al tráfico ilícito de drogas, solicitado por el Juzgado Penal colegiado de Huánuco.
Argandoña Aguirre había sido detenido el octubre del 2020, junto a Ciurlizza Argandoña Garay, en las in-
mediaciones del parque San Pedro, cuando pretendía hacer un traspaso de droga. Los policías le encontraron una bolsa conteniendo 5 kilos y 155 gramos de marihuana. El sujeto era solicitado desde el 16 de septiembre del 2022, por lo que fue intervenido en las intersecciones de los jirones Huallayco y Ayacucho en Huánuco, y luego fue trasladado a la carceleta judicial para disponer su situación legal.
policiales 13 policiales
AHORA | Viernes 05 de mayo de 2023
Sospechoso se encuentra detenido mientras se realiza las investigaciones correspondientes
Ambo, por disposición del fiscal provincial de Ambo, Marco Acuña,
León de Huánuco sacó ventaja en la primera fecha de la liguilla
Carlos Chávez se recupera satisfactoriamente

Alivio para los familiares, amistades, alumnos, exalumnos y todos quienes estaban preocupados por la salud del profesor Carlos Chávez; su salud mejora satisfactoriamente luego del grave accidente de tránsito que sufrió la semana pasada, del cual salió con quemaduras de tercer grado luego que su motocicleta se incendió cuando se trasladaba desde el Valle hacia la ciudad de Huánuco.
Carlos Chávez se encuentra internado en la Unidad de Quemados del hospital Almenara en Lima, donde el diario Aho-

N° 03, dirigido a las ligas distritales de la provincia, citándoles a una reunión para tratar el inicio y desarrollo de
la etapa provincial de la Copa Perú.
La reunión se realizará mañana sábado 6 de mayo en el audito -
rio de la Liga Departamental de Huánuco y la citación es para los presidentes de las 10 ligas distritales que organizaron campeonatos este año, así como para los representantes de los clubes ya clasificados o los que tengan más posibilidades de clasificar.
Se tomarán acuerdos para el inicio y desarrollo de la indicada etapa, como el avance de sus torneos, fecha, sistema de juego, sorteo de series y demás aspectos contemplados en el reglamento del Sistema Copa Perú.

Las 10 ligas que organizaron campeonatos son: Pillao, Chinchao, Churubamba, el Valle, Kichki, Margos, Pucuchinche, Amarilis, Pillco Marca y Huánuco.
ra se comunicó con él telefónicamente ayer y dio a conocer que se recupera satisfactoriamente, sin embargo, señaló que el tratamiento va a ser largo.
Ya le han hecho una intervención quirúrgica, la cual fue exitosa, pero el tratamiento comprende 3 operaciones más. Carlos muestra un espíritu optimista, porque las quemaduras no le han comprometido órganos vitales como creyó en un principio sino solo las piernas, los médicos le han dado la seguridad que volverá a caminar normalmente.
Expresó también su reconocimiento hacia todos quienes se están haciendo presentes con su apoyo, incluso exalumnos desde el extranjero.

Unheval y Construcción Civil empataron con final de escándalo
En el primer partido de la primera fecha de la liguilla huanuqueña, valdizanos y constructores igualaron y perdieron opciones de clasificar. Fue un partido en el que el cuadro rojo fue mejor, pero la experiencia de los universitarios les sirvió para equilibrar las acciones.
A los 28’ de la primera parte, Paul Bashi puso en ventaja a Construcción Civil con un buen tanto y el equipo pudo aumentar la cuenta pero no lo aprovechó.
En la segunda parte, me-
joró la Unheval y se animó a atacar en busca de la igualdad. Se le presentó la oportunidad a través de un penal que sancionó el árbitro, pero Arévalo falló en la ejecución.
Sin embargo, cuando corrían los 31’, una buena jugada colectiva de los valdizanos terminó en un golazo que concretó York Moreno para el empate final.
La igualdad no convenía a ninguno, porque en las dos próximas jornadas enfrentarán a los dos equipos más fuertes de la liga.
14 DEPORTES AHORA | Viernes 05 de mayo de 2023
Convocan a reunión para programar la etapa provincial de la Copa Perú
El presidente de la Liga Provincial de Fútbol de Huánuco, Luis Picón Castro, ha expedido el Oficio Múltiple
Fecha final dramática en la Liga de Chinchao
Campaña de los equipos peruanos en torneos Conmebol
Distinta suerte han tenido esta semana los equipos peruanos que participan en los torneos de la Conmebol.
El martes el Sporting Cristal se impuso por 1-0 al The Strongest de Bolivia en un duro partido disputado en el Estadio Nacional de
Lima por la Copa Libertadores. Ese mismo día, en Santiago de Chile, la U César Vallejo consiguió un importante empate 2-2 ante el Magallanes, por la Copa Sudamericana.
El miércoles, Alianza Lima cayó ante el Atlético Mineiro por 2-0 en la ciu-

dad de Belo Horizonte por la Copa Libertadores.
Los equipos peruanos cerrarán esta semana de torneos internacionales con el partido entre Universitario vs Independiente Santa Fe de Colombia por la Copa Sudamericana.
De otra parte, con gol
que ya han definido sus representantes a la etapa provincial
del peruano Luis Advíncula, Boca Juniors de Argentina venció de visita por 2-0 al Colo Colo de Chile en Santiago por la Copa Libertadores. La cadena ESPN le dedicó una nota especial destacando su actuación que fue fundamental para el triunfo del cuadro xeneize.
son: Pillco Marca: Colegio Garrido y Albino Velásquez; en Kichki: Rodeo de Margo y León de Cani juegan el domingo la definición para el campeón.
En el Valle, Independiente Huachog ya clasificó y falta el segundo. Hasta tres equipos tienen posibilidades de ganar el cupo.
En el distrito de Churubamba se clasificaron el Sporting Cristal de Tambogán y Universitario de Huarapa.
Con los 4 equipos con posibilidades de clasificar a la etapa provincial, este domingo 7 se disputará la tercera fecha del cuadrangular final de la etapa distrital de Chinchao.


La situación no es clara con respecto a quiénes tendrán un cupo, ya que luego que en la primera fecha los dos partidos terminaron empatados; en la segunda, los vencedores fueron Alianza Acomayo y 18 de Diciembre, que quedaron con 4 puntos como punteros; mientras que el Sport Man y el Sport Chinchao se quedaron con un solo punto.
La última fecha será ‘a muerte’, porque de ganar los coleros alcanzarían a los punteros y habría necesidad de definiciones en partidos extra.
En la última fecha, jugarán Sport Man vs Sport Chinchao y Alianza Acomayo vs 18 de Diciembre; si estos dos empatan se habrán clasificado, otro resultado obligaría a jugar partidos extra.
Napoli es campeón de Italia después de 33 años

Este fin de semana la mayoría de las ligas de la provincia de Huá-
nuco juegan las últimas fechas, pero no hay nada definido en cuanto a la
clasificación.
Las ligas que ya tienen sus representantes
En las ligas de Amarilis, Huánuco y Pillao están en liguillas que deben acabar la próxima semana. No hay información de las ligas de Margos y Pucuchinche.
Tres décadas después de que llegara a la gloria liderado por Diego Armando Maradona, el Napoli se proclamó campeón de la Serie A de Italia.
El equipo napolitano empató 1-1 con Udinese, en resultado que fue suficiente para asegurar matemáticamente el título y el tercer Scudetto, dejando sin posibilidades a Lazio.
Desde tempranas ho-
ras, el júbilo en las calles de la ciudad del sur de Italia anticipaba la fiesta. Había banderas, camisetas y pancartas que decían “100 % campione” por doquier. Algunos temían que la ciudad no pudiera hacer frente a una fiesta que lleva 33 años en gestación.
Los planes para una fiesta el 4 de junio, el último día de la temporada, se han adelantado por este resultado.
15 DEPORTES AHORA | Viernes 05 de mayo de 2023
Ligas
León de Huánuco sacó ventaja en la primera fecha de la liguilla
El cuadro crema se impuso al Miguel Grau, por 4-3 y dio un paso importante hacia el título de la liga huanuqueña. Fue un partidazo por la forma en que se desempeñaron ambos equipos; aunque mostraron cierto

nerviosismo, con jugadas muy intensas y los dos entregados a una dura lucha buscaron sacar adelante sus colores.
León estuvo siempre adelante en el marcador, pero cada gol provocaba la reacción
de los grauinos que de inmediato respondían sin amilanarse y empataban.


Así se desarrolló el partido hasta los 29’ del segundo tiempo, cuando se produjo el cuarto tanto crema. Algunos minutos des-
pués, el volante Isaac Talancha del Grau recibió la tarjeta roja y eso disminuyó el ímpetu del equipo y ya no pudo marcar otro gol.
La figura del partido fue el atacante Denis Alania del León, quien convirtió tres
golazos de cabeza ganándoles a los espigados defensores rivales que no encontraron la manera de controlarlo.
El marcador se movió de tal manera que el partido se tornó emocionante. Peña abrió anotó el prime -
ro a los 13’ de tiro libre ante una barrera mal colocada; Paulo Barrera igualó a los 26’ de cabeza; Alania adelantó a León a los 32’ y Alex Trujillo puso el 2-2 con que terminó la primera etapa en el mejor gol de la tarde.

16 DEPORTES AHORA | Viernes 05 de mayo de 2023


























 Edita: JTP Editores
Edita: JTP Editores